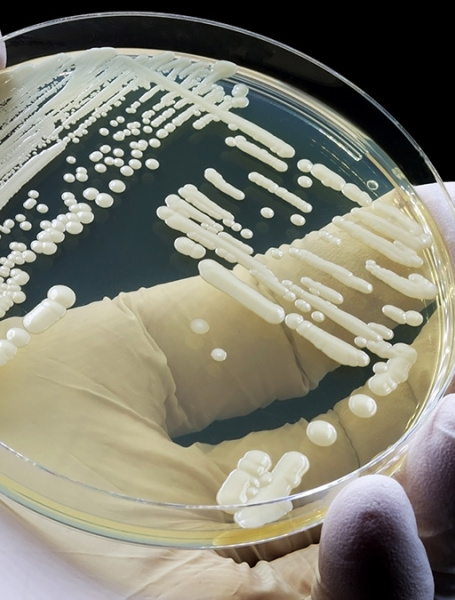
Drug resistant fungus in Dhaka hospitals

‘Nishwas’: Raihan Rafi’s compelling crime-thriller is a must-watch

After "Taan", "Floor Number 7", and "Khachar Bhitor Ochin Pakhi", Raihan Rafi has now brought forth another experimental production, "Nishwas", to the popular OTT platform, Chorki.
The one hour forty-five-minute web film—which features Tasnia Farin as its lead alongside Safa Kabir, Sayed Zaman Shawon, Rashed Mamun Apu, Neel Hurerzahan, and veteran actor Dilara Zaman—was released on Chorki this Thursday.
The film centres around the protagonist Nipa, brilliantly played by Tasnia Farin, and her struggles and turmoil in life, which later invokes her to choose extremism to get a sense of peace.
There are three major plotlines in the film, spread over three different timelines: 2014, 2015 and 2016. The major plotline revolves around the life of Nipa and her husband, portrayed by Imtiaz Barshon. The couple struggles financially after Barshon loses his job, which forces him to slowly turn to religious extremism. Farin, the sole breadwinner of the family, follows her husband and becomes an extremist herself, out of the wish to meet her lost child in heaven.
The second plotline centres around a loving couple, wonderfully portrayed by Safa Kabir and Sayed Zaman Shawon, who meets a traumatic event in their relationship and ends up at the hospital—where the third major plotline focusing on an extramarital affair between two doctors, takes place.
In several subplots of the movie, Rashed Mamun Apu, Neel Hurerzahan, and veteran actor Dilara Zaman steal the show with their brilliant acting performances. All of these characters and plotlines submerge into the climactic ending of the film wonderfully, and is likely to keep the viewers on the edge of their seats.
Tasnia Farin, delivers one of her best performances to date in this film, and viewers can easily relate to her character. She takes ownership of her character, and it reflects in her performance.
However, Imtiaz Barshon's character in the film felt a bit flat and one-dimensional at times. It would have been better if he had more character development by the end of the film. Safa Kabir's performance was vibrant, especially in scenes from the hospital's OT room. She has proven herself to be an excellent casting choice for the role.
The film's one and only fault is probably its ending. The extreme tension it builds throughout the development of the stories, somehow, gets lost somewhere. Multiple things are happening at once, and by the end, the central message of the story and the protagonist's intention diverts off-course.
Raihan Rafi, along with his costume designer and art director, has created a cinematic experience that many will remember for years to come. Along with excellent art direction, the film's colour-grading, background music, and sound mixing were soothing, yet intense, creating a perfect atmosphere for the performers to shine. Jahid Nirob, the music director, deserves applaud for his work here. However, the incongruities between dialogues and dubbing seemed out of place at times.
Merely 24 hours have passed since its release, but "Nishwas" has already received a grand reception, garnering a large viewership and much appreciation from audiences. In the coming years, it is likely that the crime-thriller will be regarded as one of the best in the genre.




 For all latest news, follow The Daily Star's Google News channel.
For all latest news, follow The Daily Star's Google News channel. 


Comments